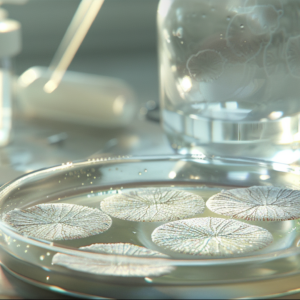
True Albino Teacher

Featured Product
Explore Our Collections
Do You Know Your Mycology Interests?

Why Choose Heady’s Genetics?
Get Reliable, High-Quality Spores Today!
Associated With:
Our Recent Products!

Years of Expertise

Unique Strains
Rhoncus At Quis
Trusted by hundreds for premium spores.


Happy Collectors

Successful Shipments
“The quality and precision of Heady’s Genetics spores are unmatched. Every order exceeds expectations.”